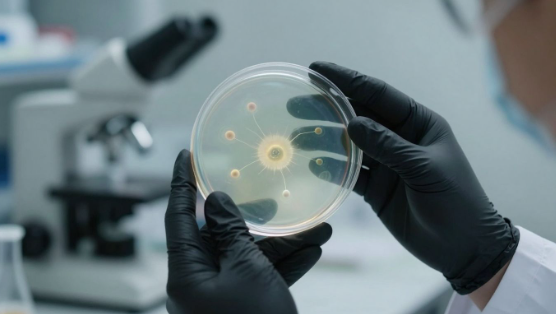

Explore stem cell therapy in Connecticut: innovations, patient stories, and regenerative medicine advancements. Learn about cutting-edge treatments.
Thinking about stem cell therapy in Connecticut? It’s a topic that’s really picking up steam, with new ways to help the body heal itself popping up all over the state. From cutting-edge research labs to actual patient stories, there’s a lot happening. We’re going to take a look at what’s new and what it means for people looking for different health solutions. For local consultations and clinic information, consider BioRestore Health.
Key Takeaways
- Connecticut is seeing a lot of new developments in stem cell therapy, with places like UConn Health and the Connecticut Convergence Institute leading the way.
- New treatments like Bio X Stem and Organicell™ Exosomes are focusing on using stem cell byproducts, like exosomes, to help the body repair itself.
- Patients are sharing their experiences, including a life-changing bone marrow transplant at UConn Health, showing the real-world impact of these therapies.
- The applications for stem cell therapy are expanding beyond just orthopedic issues, with research looking into how it might help with brain conditions, autoimmune diseases, and even eye problems.
- There’s a strong focus on making sure these regenerative medicine options are safe and high-quality, with strict guidelines for products like Organicell™ Flow.
Innovations in Stem Cell Therapy, Connecticut
Connecticut is really becoming a hub for some pretty cool advancements in how we heal ourselves. It feels like every week there’s something new happening in regenerative medicine, especially when it comes to stem cells. We’re moving beyond just thinking about these therapies for a few specific problems; the scope is getting much wider.
Cutting-Edge Regenerative Medicine Therapies
There’s a lot of work happening here to push the boundaries of what’s possible with healing. Researchers and clinics are developing new ways to use the body’s own repair mechanisms. It’s not just about using stem cells anymore, but also about understanding the signals they send. Think of it like this: instead of just sending the construction workers (stem cells), we’re also figuring out how to send them the detailed blueprints and instructions they need to do the best job possible.
The Role of Exosomes in Cellular Regeneration
This is where things get really interesting. Exosomes are tiny little packages that cells, including stem cells, release. They’re like microscopic messengers carrying important instructions. In Connecticut, there’s a growing focus on using these exosomes to help damaged tissues heal. They can tell cells what to do, where to go, and how to repair themselves, often without needing to introduce whole stem cells. It’s a more targeted approach to healing.
BIO X Stem: Supporting Tissue Repair
BIO X Stem is one of the therapies being explored and used. It’s designed to give your body a boost in its natural ability to fix itself. The idea is to support the repair of damaged tissues, whether that’s from an injury, wear and tear, or a chronic condition. It’s part of a bigger picture in Connecticut where medical professionals are looking for less invasive ways to help patients recover and feel better.
Patient Journeys with Stem Cell Treatments
UConn Health’s Lifesaving Bone Marrow Transplant
Sometimes, the most powerful stories come directly from those who have walked through a difficult health challenge and come out the other side. At UConn Health, patient experiences highlight the real-world impact of advanced medical treatments. Take Steffan Goelitzer’s story, for instance. While living in Connecticut on a work visa, he began experiencing concerning memory and balance issues. UConn Health diagnosed him with a rare form of brain lymphoma. Despite the option to return to Germany for treatment, Steffan and his wife Simone were so impressed with the Bone Marrow Transplant Unit that they chose to stay. After months of chemotherapy and a stem cell transplant, Steffan is now in remission. He and Simone consider UConn Health their second home, a testament to the care they received.
Experiencing Advanced Healing Options
Beyond major transplants, many individuals are exploring stem cell therapies for a variety of conditions, seeking ways to support their body’s natural healing. It’s not just about treating a specific disease; it’s about finding options that can help restore function and improve quality of life. For some, this means looking into treatments that support tissue repair. For example, products like Bio X Stem utilize components derived from ethically donated birth tissues. These materials are rich in things like hyaluronic acid and collagen, which are known to help with joint lubrication and tissue scaffolding. The idea is to give the body the building blocks it needs to mend itself. These advanced options are becoming more accessible, offering new hope for complex conditions.
It’s important to understand what these therapies involve. They often focus on using the body’s own regenerative capabilities. Here’s a general idea of how some of these treatments work:
- Preparation: The therapeutic materials are carefully processed to maintain their beneficial properties.
- Delivery: These components are then administered to the target area, often with the help of advanced delivery systems.
- Integration: The goal is for these components to support the body’s natural repair processes at a cellular level.
The journey of exploring regenerative medicine can feel overwhelming, but focusing on the potential for improved healing and the dedication of medical professionals can make a significant difference. Many patients find that understanding the science behind these treatments, even in simple terms, helps them feel more in control of their health decisions.
For those dealing with orthopedic issues, stem cell treatments are being looked at for conditions affecting the shoulder, knee, hip, and more. The potential extends to other areas too, with research exploring applications for neurological and autoimmune disorders. It’s a rapidly evolving field, and Connecticut is part of this innovation, with institutions and clinics working to bring these advanced therapies to patients. If you’re curious about the possibilities, looking into the work being done at places like Optimal Health Medical can provide more insight into current approaches.
Applications of Stem Cell Therapy in Connecticut

Orthopedic Care and Pain Relief
Stem cell therapy has really made a name for itself in helping people with joint pain and injuries. Think about common issues like knee pain, shoulder problems, or even hip and elbow discomfort. Instead of just masking the pain, these treatments aim to help your body actually repair itself. It’s pretty neat how they can potentially encourage damaged tissues to heal. Many folks in Connecticut are finding relief through these advanced methods, getting back to activities they love without constant aches.
Potential for Neurological and Autoimmune Disorders
This is where things get really interesting, and honestly, a bit more experimental. For conditions like Parkinson’s, Multiple Sclerosis, or even Crohn’s disease, where traditional treatments can be limited, stem cells are showing some promise. Researchers are looking into how these cells might help repair damaged nerves or calm down an overactive immune system. It’s not a magic bullet yet, and there’s a lot of research still happening, but the potential to help people with these tough conditions is a big deal.
Exploring New Frontiers in Ophthalmology Research
Believe it or not, stem cells are even being looked at for eye conditions. While it might sound like something out of a sci-fi movie, scientists are exploring how stem cells could help with certain vision problems. The idea is to see if they can help repair damaged parts of the eye or even create better models to study eye diseases. It’s still early days, and results are mixed, but it’s a fascinating area where Connecticut researchers are pushing boundaries to find new ways to preserve sight.
Pioneering Research and Development
Connecticut Convergence Institute’s Contributions
The Connecticut Convergence Institute is a hub for groundbreaking work in regenerative medicine. They’ve been instrumental in supporting young scientists, with their BUILDing Scholars program seeing participants like Isaac Gandara and Diana Moreno achieve top honors at symposia. These students presented research on topics ranging from microRNA targets in osteoclasts to health disparities in prostate cancer, showcasing the breadth of scientific inquiry happening in the state. The institute actively fosters an environment where new ideas can take root and grow.
Advancements in Biologic Medicine
Research in biologic medicine is rapidly expanding, and Connecticut is at the forefront. Scientists are exploring how extracellular vesicles (EVs), tiny packages released by cells, can be used for healing. For instance, studies are looking into EVs derived from induced pluripotent stem cells (hiPSCs) and bone marrow stem cells (MSCs) as potential treatments for conditions like bronchopulmonary dysplasia (BPD) in premature infants. The goal is to see if these EVs can help repair lung tissue and improve outcomes.
The Science Behind Growth Factors and Cytokines
Growth factors and cytokines are signaling molecules that play a big role in how our cells communicate and repair themselves. Researchers are investigating how to harness these natural processes. Think of them as messengers that tell cells what to do, like encouraging tissue repair or reducing inflammation. Understanding these signals is key to developing new therapies that can guide the body’s own healing mechanisms more effectively. This area of study is complex, but it holds a lot of promise for treating a wide range of conditions.
The focus is on understanding the body’s natural repair systems and finding ways to support or amplify them. It’s less about introducing something entirely foreign and more about working with what’s already there, just perhaps giving it a helpful nudge in the right direction.
Understanding Regenerative Medicine Options
Organicell™ Flow: A Next-Generation Solution
When we talk about regenerative medicine, it’s not just about stem cells anymore. There’s a whole new wave of treatments emerging, and Organicell™ Flow is a prime example. Think of it as a super-charged fluid, derived from amniotic fluid, that’s packed with tiny cellular messengers called exosomes. These exosomes are like little couriers, carrying important signals that tell your body how to repair itself. It’s pretty amazing stuff, really. This isn’t just a simple solution; it’s a complex biological product designed to support your body’s natural healing.
Organicell™ Flow contains a massive amount of these exosomes – we’re talking over 52.6 billion per milliliter. On top of that, it’s loaded with growth factors and cytokines, which are like the construction crew and the foremen of cellular repair. They help reduce inflammation and guide the whole healing process. It also includes other helpful components like chemokines, hyaluronic acid, and even microRNAs, all working together to keep your cells healthy and promote tissue regeneration. It’s a really thorough approach to healing.
Non-Invasive Alternatives for Complex Conditions
For a lot of people dealing with chronic pain or conditions that don’t respond well to traditional medicine, the idea of surgery or heavy medication can be pretty daunting. Regenerative medicine, especially treatments like those using exosomes, offers a different path. These therapies are generally non-invasive, meaning they don’t require surgery. Instead, they often involve simple injections or infusions. This makes them a much more appealing option for many patients who want to avoid the risks and downtime associated with surgical procedures. It’s about working with your body’s own systems to get better, rather than fighting against them.
It’s important to know that these advanced treatments aren’t typically covered by insurance yet. That’s a hurdle for some, but it also highlights how cutting-edge this field is. The focus is on providing innovative ways to manage difficult health issues, offering hope where other options might have fallen short. It’s a big step forward in how we think about treating complex health problems.
Commitment to Quality and Safety in Allografts
When you’re considering treatments that involve donated biological materials, like allografts, quality and safety are absolutely paramount. Products like Organicell™ Flow are made with really strict guidelines in mind. They follow regulations set by organizations like the American Association of Tissue Banks (AATB) and the U.S. Food and Drug Administration (FDA). This means there’s a lot of careful screening and testing involved.
Here’s a quick look at what goes into making sure these products are safe:
- Donor Screening: Potential donors go through a thorough health check. This includes making sure they give full consent and are tested for various diseases, including Hepatitis B, Hepatitis C, and HIV.
- Ethical Sourcing: The materials are sourced responsibly, ensuring everything is handled ethically.
- Rigorous Testing: All the donated materials are screened extensively to confirm they are free from transmissible diseases.
- Sterile Processing: The final product, like Organicell™ Flow, is sterile-filtered to ensure it’s safe for use.
This dedication to safety and quality means that patients can feel more confident about the treatments they are receiving. It’s about building trust in these advanced biological therapies and making sure they are as effective and safe as possible for everyone who needs them.
Looking Ahead: The Future of Stem Cell Therapy in Connecticut
So, what’s next for stem cell therapy here in Connecticut? It’s clear that a lot is happening, from cutting-edge research at places like UConn Health to innovative treatments being offered by clinics. We’ve heard about how these therapies are helping people with tough conditions, like the patient who received a life-saving bone marrow transplant. While there’s still a lot to learn, especially in areas like neurological diseases where results are still being figured out, the progress is undeniable. Whether it’s using exosomes or other advanced methods, the focus seems to be on harnessing the body’s own healing power. It’s an exciting time for regenerative medicine in the state, and it looks like more and more people will have access to these new options for improving their health.
